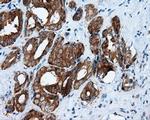
RALBP1 Antibody in Immunohistochemistry (Paraffin) (IHC (P))

Search
OriGene
RALBP1 Monoclonal Antibody (OTI1E2), TrueMAB™
{{$productOrderCtrl.translations['antibody.pdp.commerceCard.promotion.promotions']}}
{{$productOrderCtrl.translations['antibody.pdp.commerceCard.promotion.viewpromo']}}
{{$productOrderCtrl.translations['antibody.pdp.commerceCard.promotion.promocode']}}: {{promo.promoCode}} {{promo.promoTitle}} {{promo.promoDescription}}. {{$productOrderCtrl.translations['antibody.pdp.commerceCard.promotion.learnmore']}}
产品信息
TA500952
种属反应
宿主/亚型
分类
类型
克隆号
抗原
偶联物
形式
浓度
纯化类型
保存液
内含物
保存条件
运输条件
靶标信息
Can specifically activate hydrolysis of GTP bound to RAC1 and CDC42, but not RALA. Mediates ATP-dependent transport of S-(2,4-dinitrophenyl)-glutathione (DNP-SG) and doxorubicin (DOX) and is the major ATP-dependent transporter of glutathione conjugates of electrophiles (GS-E) and DOX in erythrocytes. Can catalyze transport of glutathione conjugates and xenobiotics, and may contribute to the multidrug resistance phenomenon. Serves as a scaffold protein that brings together proteins forming an endocytotic complex during interphase and also with CDC2 to switch off endocytosis, One of its substrates would be EPN1/Epsin.
仅用于科研。不用于诊断过程。未经明确授权不得转售。
篇参考文献 (0)
生物信息学
蛋白别名: 76 kDa Ral-interacting protein; Dinitrophenyl S-glutathione ATPase; DNP-SG ATPase; Ral-interacting protein 1; RalA-binding protein 1; RalBP1; RIP
基因别名: RALBP1; RIP1; RLIP; RLIP1; RLIP76
UniProt ID: (Human) Q15311
Entrez Gene ID: (Human) 10928